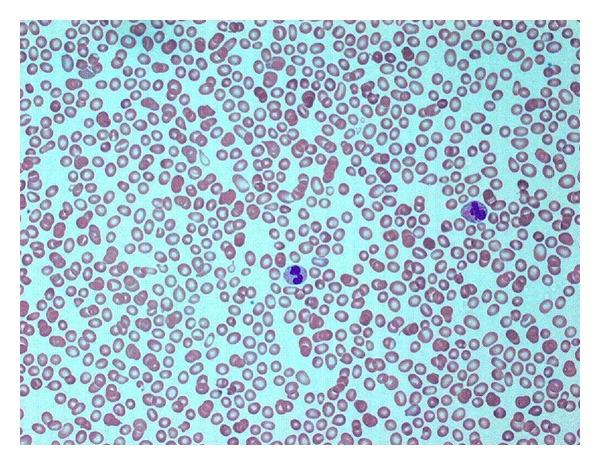

Myelodysplastic Syndrome with t(1;7) Associated with Marked Dysmegakarypoiesis & Severe Thrombocytopenia: A Case Report and Review of the Literature.
作者信息
Gilbertson Michael, Tuckfield Annabel, Juneja Surender
机构信息
Department of Diagnostic Haematology, The Royal Melbourne Hospital, Parkville, VIC 3050, Australia.
出版信息
Case Rep Hematol. 2012;2012:167653. doi: 10.1155/2012/167653. Epub 2012 Apr 12.
Abstract
We present the case of a 70-year-old woman who had a bone marrow examination performed to investigate marked thrombocytopenia in the context of a recent history of metastatic glucagonoma. Surprisingly this identified marked dysmegakaryopoiesis and fulfilled diagnostic criteria for refractory cytopenia with multilineage dysplasia, with a relatively uncommon associated cytogenetic lesion t(1;7). We present the case and review the literature of this cytogenetic lesion.
摘要
相似文献
1
Myelodysplastic Syndrome with t(1;7) Associated with Marked Dysmegakarypoiesis & Severe Thrombocytopenia: A Case Report and Review of the Literature.
Case Rep Hematol. 2012;2012:167653. doi: 10.1155/2012/167653. Epub 2012 Apr 12.
2
Membranous glomerulonephritis in a patient with myelodysplastic syndrome-refractory cytopenia with multilineage dysplasia.
Kidney Res Clin Pract. 2013 Sep;32(3):134-7. doi: 10.1016/j.krcp.2013.06.001. Epub 2013 Jul 10.
3
Differences in the bone marrow histology between childhood myelodysplastic syndrome with multilineage dysplasia and refractory cytopenia of childhood without multilineage dysplasia.
Histopathology. 2019 Jan;74(2):239-247. doi: 10.1111/his.13721. Epub 2018 Oct 29.
4
Refractory Thrombocytopenia with Multilineage Dysplasia: A Rare Type of Myelodysplastic Syndrome.
Turk J Haematol. 2003 Mar 5;20(1):25-30.
5
6
Isolated deletion of the long arm of chromosome 20 [del(20q12)] in myelodysplastic syndrome: a case report and literature review.
Singapore Med J. 2013 Sep;54(9):e185-9. doi: 10.11622/smedj.2013119.
7
Refractory thrombocytopenia with chromosome 11q23 abnormality.
Ann Hematol. 1996 Aug;73(2):99-102. doi: 10.1007/s002770050209.
8
A new disease categorization of low-grade myelodysplastic syndromes based on the expression of cytopenia and dysplasia in one versus more than one lineage improves on the WHO classification.
Leukemia. 2007 Apr;21(4):668-77. doi: 10.1038/sj.leu.2404564. Epub 2007 Feb 15.
9
[Myelodysplastic syndrome classification].
Ann Biol Clin (Paris). 2013 Mar-Apr;71(2):139-44. doi: 10.1684/abc.2013.0804.
10
A prognostic impact of separation of refractory cytopenia with multilineage dysplasia and 5q- syndrome from refractory anemia in primary myelodysplastic syndrome.
Leuk Res. 2003 Mar;27(3):221-9. doi: 10.1016/s0145-2126(02)00096-6.
引用本文的文献
1
Role of conventional cytogenetics in sequential karyotype analysis of myelodysplastic syndrome: a patient with der(1;7)(q10;p10).
Hematol Transfus Cell Ther. 2019 Jan-Mar;41(1):91-94. doi: 10.1016/j.htct.2018.05.009. Epub 2018 Jul 17.
本文引用的文献
1
Does MDS with der(1;7)(q10;p10) constitute a distinct risk group? A retrospective single institutional analysis of clinical/pathologic features compared to -7/del(7q) MDS.
Cancer Genet Cytogenet. 2009 Sep;193(2):78-85. doi: 10.1016/j.cancergencyto.2009.04.013.
2
Outcome of treating advanced neuroendocrine tumours with radiolabelled somatostatin analogues.
Clin Transl Oncol. 2009 Jan;11(1):48-53. doi: 10.1007/s12094-009-0310-5.
3
Radioembolization with selective internal radiation microspheres for neuroendocrine liver metastases.
Cancer. 2008 Sep 1;113(5):921-9. doi: 10.1002/cncr.23685.
4
Peptide Receptor Radionuclide Therapy with radiolabelled somatostatin analogues in patients with somatostatin receptor positive tumours.
Acta Oncol. 2007;46(6):723-34. doi: 10.1080/02841860701441848.
5
Unbalanced translocation der(1;7)(q10;p10) defines a unique clinicopathological subgroup of myeloid neoplasms.
Leukemia. 2007 May;21(5):992-7. doi: 10.1038/sj.leu.2404619. Epub 2007 Feb 22.
6
Diagnostic challenge of glucagonoma: case report and literature review.
Endocr Pract. 2006 Jul-Aug;12(4):422-6. doi: 10.4158/EP.12.4.422.
7
The unbalanced 1;7 translocation in de novo myelodysplastic syndrome and its clinical implication.
Cancer. 1990 Mar 15;65(6):1350-4. doi: 10.1002/1097-0142(19900315)65:6<1350::aid-cncr2820650617>3.0.co;2-j.